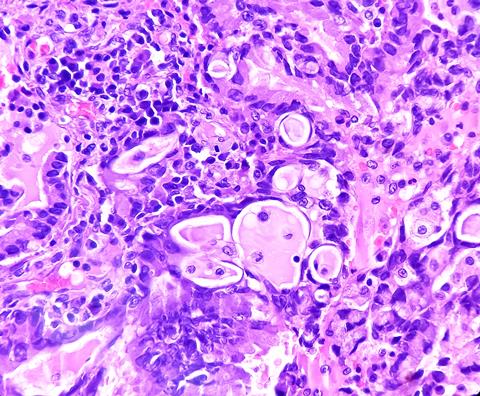
Lung,Cancer,-,Adenocarcinoma,,Mucinous,Type.,Therapies,For,Specific,Genetic

Disrupting the mechanism that EGFR-driven lung adenocarcinoma uses to alter macrophages’ lipid metabolism could inspire new treatments.
Scientists at the Salk Institute have found that the epidermal growth factor receptor (EGFR)-driven lung adenocarcinoma uses macrophages, changing their lipid metabolism to make them cancer fuel-suppliers. The findings could inspire novel interventions that disrupt this tumour cell-macrophage relationship.
Lung adenocarcinoma is the most common lung cancer and the cause of most cancer-related deaths in the United States. It can arise in multiple ways, one of which is a mutation in the EGFR protein. Non-mutated EGFR aids cell growth in response to injury, but mutated EGFR promotes out-of-control growth that can turn into cancer.
EGFR-driven lung adenocarcinoma does not respond to modern immunotherapies and although some drugs exist to treat it, patients usually develop a resistance to them within a few years. Macrophages are lung-resident immune cells designed to dispose of diseased and damaged cells and maintain a balance of protective lipids around lung alveoli. Lung adenocarcinoma uses macrophages, pulling them into the tumour microenvironment (TME) and altering their lipid metabolism. Then, the newly energised tumour cells cause further macrophage proliferation to supply more fuel.
Dr Susan Kaech, professor, director of the NOMIS Center for Immunobiology and Microbial Pathogenesis, and holder of the NOMIS Chair at Salk, explained: “We have discovered a novel way that lung cancer cells manipulate their local environment and other cell types surrounding them to promote their own growth. In this case, the tumour cells exploit lung-resident macrophages—remodelling them to provide nutrients, like cholesterol, to the cancer cells and stimulate tumour growth.”
She added: “One exciting implication of this work is that lung cancer treatments may be improved by simply adding statins, an already widely used class of drugs, to the patient’s treatment plan.”
Alveoli health relies upon a lipid-rich environment created by alveolar cells and sustained by macrophages. Maintaining the lipid balance becomes more complicated when tumour cells begin to exploit lipids to help themselves grow. Therefore, a greater understanding of the mechanisms macrophages use to regulate their metabolism and lipid production can offer insight into how tumour cells manipulate those mechanisms.
Dr Alexandra Kuhlmann-Hogan, first author, former postdoctoral researcher in Dr Kaech’s lab and current postdoctoral researcher at UCLA, elucidated: “The tumour cells excrete even more of a growth factor called GM-CSF (granulocyte macrophage colony-stimulating factor), which then causes the macrophages to grow alongside them and change their metabolism, resulting in excess lipids that the tumour cells use to strengthen themselves…The cancer was effectively hijacking this normal macrophage process of maintaining the lungs with healthy lipids in order to fuel itself.”
“Not only were the tumour cells metabolically reprogramming the macrophages—they were also instigating a feedback loop that encouraged an optimal metabolic state in the tumour cells themselves,” commented co-corresponding author Dr Katerina Politi, scientific director of the Center for Thoracic Cancers at Yale Cancer Center and professor of pathology at Yale School of Medicine.
When the EGFR-driven lung adenocarcinoma cells secreted GM-CSF, it stimulated a gene in the macrophages named peroxisome proliferator-activated receptor gamma (PPARγ) which initiated their metabolic reprogramming and subsequent secretion of lipids. Also, the tumour cells use the lipids to power the continued activation of the EGFR-drive that helps the cancer grow.
Dr Kaech predicted that disrupting this loop could be a novel intervention for slowing down EGFR-driven cancer growth. However, the exact mechanism of how the delivery of lipids like cholesterol to tumour cells powers the EGFR oncogenic pathway is still uncertain.
Co-corresponding author Dr Christian Metallo, professor and holder of the Daniel and Martina Lewis Chair at Salk, said: “We have identified a key metabolic relationship between macrophages and alveoli that is exploited by tumour cells to support the cancer’s metabolic demands—now we just have to disrupt that exploitation.”
The team recommend pairing PPARy inhibitors with statins in future clinical trials. Similar immunological hijacking happens in other TMEs around the body, indicating that these findings could mean further discoveries across other cancer types and immune cells.
The study was published in Cancer Discovery.


